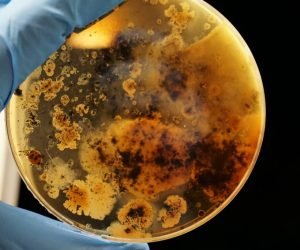
Fear of Germs

At Sydney Phobia Therapy, we specialize in helping you overcome your fears with proven techniques tailored to your needs. Whether it’s fear of heights, public speaking, or any other phobia, we guide you toward lasting change—so you can turn your problem into a solution and regain your confidence.
If you want to remove any constraints that are blocking you, you are in the right place. Craig Chitty has been passionate about Hypnotherapy for many years and has backed his passion up with very credible qualifications. He works in partnership with his clients to clear their issues, and is extremely effective at helping his clients identify their limiting beliefs.

If you want to remove any constraints that are blocking you, you are in the right place. Craig Chitty has been passionate about Hypnotherapy for many years and has backed his passion up with very credible qualifications. He works in partnership with his clients to clear their issues, and is extremely effective at helping his clients identify their limiting beliefs.
With working in Psychotherapy and Hypnotherapy, Craig has a deep and sincere understanding of human nature, and takes a humanistic approach in his group, and one-to-one work. He is a Clinical Hypnotherapist who has completed training in Hypnosis Level 2, and Medical Hypnosis Level 1. Craig has also completed Time Base Technique Level 2 and is an NLP (neuro linguistic programming) Master Practitioner! Incidentally, he also has a First Aid Certificate. You could not be in safer hands!
Anxiety is a natural response to stress but can become excessive and interfere with daily life. It can be caused by genetics, brain chemistry, life events, and personality traits.
A psychological response to distressing or life-threatening events. Trauma-focused therapy, including Cognitive Behavioral Therapy (CBT) and EMDR (Eye Movement Desensitization and Reprocessing)
Anxiety is a natural response to stress but can become excessive and interfere with daily life. It can be caused by genetics, brain chemistry, life events, and personality traits.
A psychological response to distressing or life-threatening events. Trauma-focused therapy, including Cognitive Behavioral Therapy (CBT) and EMDR (Eye Movement Desensitization and Reprocessing)
Just want to thank Craig for our session, it has helped me a lot, however, still a long way to go but now I know a technique to do at home to continue with the process.
I had a session with Craig that helped me to re-frame a long-standing problem that had been holding me back for quite a while. It’s a work-in-progress but I’m moving forward.
We understand and help those with anxiety disorders and phobic reactions and we are able to distinguish the very clear differences between fears and phobias. We do not ‘treat’ them. We help clients get past them, leave them behind and be free of them in order to live the life they want.
There are so many different phobias, how can we be sure to manage them all? Sydney Phobia Therapy knows how to profile each client individually so that their therapy is individually tailored. Different triggers and aspects particular to the client are diminished and replaced with new more beneficial responses, aiding the client in a clear-headed future.
A very common phobia is social phobia which is also called social anxiety disorder. Does the client want to feel fear and anxiety in social situations? Of course not. Sydney Phobia Therapy uses specific reprogramming methods and non-invasive techniques to help the client be rid of distress and behaviours which compromise their day to day living.
Hypnosis is fascinating as it allows the mind to make changes in a non-reactive environment. There are four different ways of enhancing the natural state of hypnosis. Hypnotherapy is intrinsic to Sydney Phobia therapy. Using astute profiling, we assist phobia management through trance work .
Sydney Phobia Therapy recognises how one anxious thought can spread throughout your mind and change the way you think. Thankfully, this doesn’t have to be a permanent state of being and change can come about as quickly as a phobia might have appeared. This is because we learn quickly. We can unlearn quickly. The ‘plastic’ nature of the brain allows us to make the most of our conscious and subconscious mind.
Sydney Phobia Therapy recognises how situations you could manage in the past now may begin to make you worry. It doesn’t matter why. What is important is the what and the how. What is the problem and how we are going to deal with it.
A common phobia consists of the fear being judged, criticised, laughed at or humiliated in front of others, even in the most ordinary, everyday situations. Whilst Therapyal hypnosis maybe the vehicle of delivery, precision language patterns are used to negate the effects of the different aspects of the phobia. Phobias like onions have layers and each person has their own individual experiences that build, like layers in the mind. Sometimes these layers have embedded commands to feel a specific way. Unlocking the negative commands is the playground of Neuro linguistic programming.
Neuro Linguistic programming (NLP) is the use of intelligent and specific language patterns to undo negative anchors and in this case, phobias in our lives. Phobias may occur at all ages and in any situations. They can come about through low blood sugar, tiredness, fight or flight responses and when NLPis used, it feels like a conversation is taking place. This conversation will happen both in a conscious state and in a trance state and can undo the phobia whether it is social phobia, coulrophobia or agoraphobia and all the phobias in between. The delivery is the same, the content is precise and specific to the client.
Dealing with phobias means that we have to be anxiety specialists. Our aim is to steer our clients away from self medication like excessive drinking, different drug dependence and obsessive compulsive behaviour to control the fear and instead, lead the clients into free thinking and logical responses to life’s experiences.
Phobia Management is possible when you take accountability for your own feelings. ‘YES! I have a phobia,’ is a good start and from there, we can help you either in person or online. Be surprised and happy that online therapy is both effective and available from Sydney Phobia Therapy. Online therapy has the bonus of being able to reach your therapist from anywhere in the world and still receive top class attention. Hypnosis is a natural altered state and can be achieved anywhere you are. A good therapist can help you bring about change both in person and online. Meeting your needs makes you feel much more in control which is where we want you to start your journey into the freedom of being phobia free.
It’s quite easy to determine. If the fear has become excessive and unreasonable and a person feels they are unable to change or control the feelings or behaviour the chances are that they are suffering from a phobia.
Phobias can significantly negatively impact daily life including work, education, family and social life. Another drawback is that undiagnosed phobias can lead to depression or feelings of hopelessness, loss of control and further anxieties.
Depression is characterised by a persistent low mood (longer than three weeks), loss of pleasure, hopelessness about the future, feelings of worthlessness, and a number of physical symptoms, including sleep and appetite disturbance. Sometimes people also experience thoughts of suicide. It might seem crazy to you that this is due to a phobia. Sydney Phobia Therapy takes it seriously. We want you to be able to live your best life and this is achievable once you remove what’s holding you back.
Low Self-Esteem is a surprising side effect of harbouring and maintaining phobias. Coping with severe anxiety for most of your life will absolutely effect your self-esteem. Even phobias like animal phobia can lead to you becoming socially isolated if your friends have animals as pets.
Yes, phobias can be effectively managed and, in many cases, eliminated with the right therapeutic approach. Sydney Phobia Therapy uses proven techniques to help you gradually overcome your fears and regain control.
The duration of treatment depends on the severity of the phobia and individual response to therapy. Some people see improvement in just a few sessions, while others may require more time for lasting results.
No, medication is not always necessary. Many people successfully manage their phobias through therapy alone. However, in severe cases, a combination of therapy and medication may be recommended by a healthcare professional.
At Sydney Phobia Therapy, we use evidence-based techniques such as Cognitive Behavioral Therapy (CBT), Exposure Therapy, and relaxation strategies to help you confront and manage your fears in a safe and controlled manner.
Most phobias are not based on logical reasoning, but that doesn’t mean they aren’t real. If your fear is affecting your daily life, it’s important to seek help. Our therapy sessions focus on helping you regain confidence and reduce anxiety.
Yes! Phobias can affect people of all ages. Our therapy is tailored to suit both children and adults, ensuring that each individual receives the best possible approach for their specific needs.
Don’t let phobias control your life. At Sydney Phobia Therapy, we offer proven techniques to help you overcome your fears with confidence.
Book your consultation today and start your journey toward freedom!